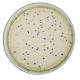
Rainbown Transformation, Manufacturer reference: 224

DNA Fingerprinting - Using Restriction Enzymes, Manufacturer reference: 225
ABOUT THIS PRODUCT:
Teach your students about restriction enzyme digests in the context of forensic science! Your students will cut DNA with restriction enzymes and then compare the banding pattern of the crime scene DNA versus that of two suspects using agarose gel electrophoresis.
DOWNLOAD SAMPLE INSTRUCTIONS
DOWNLOAD SAMPLE INSTRUCTIONS
€165.00
SKU
EDV_225

Details
Group Size:
For 6 gels
Time Required:
Complete in 1 hour 20 minutes to 1 hour 45 minutes
Kit Includes:
Instructions, “crime scene” and "suspect" Ready-to-Load™ DNA samples, DNA Standard Marker, Dryzymes® - Eco RI and Hind III, Enzyme Reaction Buffer, Reconstitution Buffer, Enzyme Grade Water, UltraSpec-Agarose™, 10X Gel Loading Solution, 50X Concentrated Electrophoresis Buffer, Practice Gel Loading Solution, InstaStain™ Blue Cards, FlashBlue™ DNA Stain, Disposable Pipets, & Microcentrifuge Tubes.
All You Need:
DNA Electrophoresis, Micropipettes: 5-50 µl, Water Bath, White Light Box, & Microwave or Hot plate.
Storage:
Some Components Require Freezer Storage Upon Receipt
Replenisher:
- #225 FB - EDVO-Kit #225 Replenisher (Comp. A-J)
Resource
Quick Guides:
Safety Data Sheets:
Instructional Videos:
| Manufacturer | Edvotek Inc. |
|---|---|
| Size / Rxns Number: | No |
| Protocol & Manual | No |
| Technical Tips | No |
Write Your Own Review